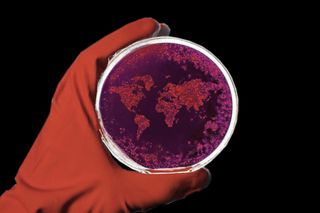

Flu‑Like Viral Pandemic Will Soon Kill 80 Million, Wipe Out 5% of World Economy
We are not prepared for a global disease outbreak, according to an international group of health experts.
A pandemic with the potential to sweep across the globe in three days — capable of killing 80 million people and wiping out 5% of the world’s economy — is imminent. It could start anywhere in the world, but it will most likely begin as a flu-like, viral epidemic, with one person passing an airborne pathogen to the next, until it reaches the devastation levels of the 1918 influenza pandemic. Many national health systems will collapse, with low resource communities being hit the hardest.
This is only a matter of time, a matter of when — not if — according to the first report by the Global Preparedness Monitoring Board (GPMB), an independent body made up of health and emergency-response experts from around the world, co-convened by the World Health Organization and the World Bank. “There’s widespread agreement that it’s virtually certain we are going to be facing another epidemic, or pandemic. The question is how soon — it could be many years. It could be next year,” Scott Dowell, an expert on outbreak response at the Bill & Melinda Gates Foundation, said to Fast Company.
Are we prepared for such a global disease outbreak of catastrophic proportions? The GPMB says: no.
The problem
With increased globalization and mobility, unprepared health facilities, dire risks of widespread epidemics like Ebola, and the possibility of weaponizing a disease, “a quick-moving pathogen has the potential to kill tens of millions of people, disrupt economies, and destabilize national security. Climate change, urbanization, and a lack of adequate water and sanitation are all breeding grounds for fast-spreading, catastrophic outbreaks,” the GPMB said in a press release upon the launch of the report titled “A World At Risk: Annual Report on Global Preparedness for Health Emergencies.”
The GPMB took up the task of creating this report after the outbreak of Ebola in West Africa between 2014 and 2016 that has already resulted in close to 2,000 deaths in the Democratic Republic of Congo. Recognizing that “epidemic-prone diseases like Ebola, influenza, and severe acute respiratory syndrome (SARS) are becoming increasingly difficult to manage due to prolonged conflict in the areas where it’s spreading, fragile states, and forced migration,” the GPMB set about to explore and identify the most pressing needs and tangible actions required to accelerate countries’ preparedness for health emergencies. The GPMB analyzed the World Bank’s and the WHO’s data on economies, the state of poverty, epidemics and pandemics, and the quality of health care across the world, and reviewed seven commissioned papers exploring the challenges of countries’ preparedness. It, then, arrived at concrete steps leaders can take to prepare for and manage the fallout of a high-impact global disease outbreak.
Related on The Swaddle:
Good and Bad News About India’s Zika Virus Outbreak
The impact
Apart from 80 million people dying within 36 hours — almost the population of Germany today — the economic consequences of an epidemic or pandemic on the scale predicted will be calamitous. “The World Bank estimates that a global influenza pandemic akin to the scale and virulence of the one in 1918 would cost the modern economy $3 trillion, or up to 4.8% of gross domestic product (GDP); the cost would be 2.2% of GDP for even a moderately virulent influenza pandemic,” according to the report.

Estimated costs of selected global epidemics/pandemics in US$ billions (2001-2017)
Source: GPMB 2019 Annual Report
Additionally, the disease will disproportionately hit lower-resourced communities much harder — disease thrives in disorder, poverty, and fragility — given their lack of access to basic health services, clean water, and sanitation, which will further accelerate the spread of the pathogen. While developed countries like the U.S. and Australia will lose up to 0.5% of their GDP only, most countries in the developing world such as Guinea, Liberia, Sierra Leone, India, and Pakistan will lose as much as2% of their GDP.
The solution
“For too long, world leaders’ approaches to health emergencies have been characterized by a cycle of panic and neglect,” Dr. Gro Harlem Brundtland, co-chair of the GPMB, said in the press release. “It is high time for urgent and sustained action. This must include increased funding at the community, national and international levels to prevent the spread of outbreaks. It also requires leaders to take proactive steps to strengthen preparedness coordination mechanisms across governments and society to respond quickly to an emergency.”
The first step, the report suggests, is for leaders of countries to implement their binding obligations under the International Health Regulations — such as inspecting international cargo and ensuring travelers are properly vaccinated. “All 195 countries in the world signed on to prepare according to the International Health Regulations back in 2005,” Dowell said to Fast Company, “but as of last year, less than a third of the countries reported that they’ve achieved the preparedness they committed to.”
The next step urges all countries to set up a national-level coordinator with the political authority to conduct whole-of-government and whole-of-society level drills, should the pandemic hit. Additional steps include investing in “developing innovative vaccines and therapeutics, surge manufacturing capacity, broad-spectrum antivirals and appropriate non-pharmaceutical interventions … [and developing] a system for immediately sharing genome sequences of any new pathogen.” Lastly, the report calls for intergovernmental organizations and donors to increase relevant donations to medical and emergency fields and for the United Nations to improve its emergency response coordination.
Related on The Swaddle:
What You Need To Know About Swine Flu
At the core of it all lies the political will to take definitive action. As of last month, more than 100 countries have agreed to let a group of international experts assess their preparedness for a rapidly spreading global disease outbreak. Resolve to Save Lives, an initiative by U.S. nonprofit Vital Strategies, has created a readiness “scorecard” for these countries. While Australia and South Korea are best prepared for such an outbreak, with respective scores of 92, Chad got the lowest score at 29.
India has not agreed to be assessed by this group yet. Unfortunately, willful denialism is not the way forward in the face of increasingly infectious disease outbreaks, which, according to the report, threaten lives and entire economies as much as climate change and natural disasters do.
Between 2011 and 2017, the WHO recorded 1,483 epidemic events in 172 countries. Epidemic-prone diseases such as influenza, SARS, Ebola, Zika,
yellow fever, and others, are among a new era of high-impact, fast-spreading global disease outbreaks that are increasingly being detected and even, re-emerging.

Global examples of emerging and re-emerging diseases
Source: GPMB 2019 Annual Report
Of these, “Ebola, cholera, measles — the most severe disease outbreaks usually occur in the places with the weakest health systems,” WHO Director-General Dr. Tedros Adhanom Ghebreyesus said during the launch. “As leaders of nations, communities and international agencies, we must take responsibility for emergency preparedness, and heed the lessons these outbreaks are teaching us. We have to ‘fix the roof before the rain comes.’”
Pallavi Prasad is The Swaddle's Features Editor. When she isn't fighting for gender justice and being righteous, you can find her dabbling in street and sports photography, reading philosophy, drowning in green tea, and procrastinating on doing the dishes.
Related


Caregivers of People Living With Mental Health Conditions Need Care, Too
